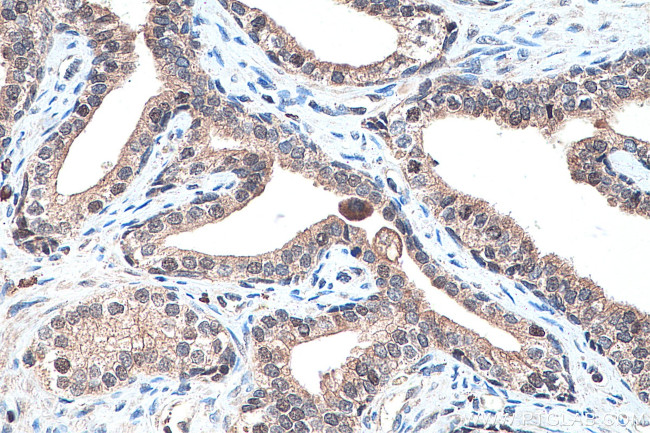
PPAR Gamma Antibody in Immunohistochemistry (Paraffin) (IHC (P))

Search
Proteintech
PPAR Gamma Polyclonal Antibody
{{$productOrderCtrl.translations['antibody.pdp.commerceCard.promotion.promotions']}}
{{$productOrderCtrl.translations['antibody.pdp.commerceCard.promotion.viewpromo']}}
{{$productOrderCtrl.translations['antibody.pdp.commerceCard.promotion.promocode']}}: {{promo.promoCode}} {{promo.promoTitle}} {{promo.promoDescription}}. {{$productOrderCtrl.translations['antibody.pdp.commerceCard.promotion.learnmore']}}
产品信息
22061-1-AP
种属反应
宿主/亚型
分类
类型
抗原
偶联物
形式
浓度
规格
纯化类型
保存液
内含物
保存条件
运输条件
产品详细信息
Aliquoting is unnecessary for -20°C storage.
靶标信息
This gene encodes a member of the peroxisome proliferator-activated receptor (PPAR) subfamily of nuclear receptors. PPARs form heterodimers with retinoid X receptors (RXRs) and these heterodimers regulate transcription of various genes. Three subtypes of PPARs are known: PPAR-alpha, PPAR-delta, and PPAR-gamma. The protein encoded by this gene is PPAR-gamma and is a regulator of adipocyte differentiation. Additionally, PPAR-gamma has been implicated in the pathology of numerous diseases including obesity, diabetes, atherosclerosis and cancer. Alternatively spliced transcript variants that encode different isoforms have been described.
仅用于科研。不用于诊断过程。未经明确授权不得转售。
生物信息学
蛋白别名: HUMPPARG; Nuclear receptor subfamily 1 group C member 3; OTTHUMP00000185032; OTTHUMP00000185036; peroxisome proliferator; peroxisome proliferator activated receptor; peroxisome proliferator activated receptor gamma; peroxisome proliferator activated receptor gamma 2; peroxisome proliferator activated receptor gamma 4; peroxisome proliferator activator receptor, gamma; Peroxisome proliferator-activated receptor gamma; peroxisome proliferator-activated receptor-gamma 5; peroxisome proliferator-activated receptor-gamma splicing; PPAR gamma; PPAR-gamma; PPARy; unnamed protein product
基因别名: CIMT1; FPLD3; GLM1; NR1C3; PPAR-gamma; PPAR-gamma2; PPARG; PPARG1; PPARG2; PPARG5; PPARgamma; PPARgamma2
UniProt ID: (Human) P37231, (Mouse) P37238, (Rat) O88275
Entrez Gene ID: (Human) 5468, (Mouse) 19016, (Rat) 25664